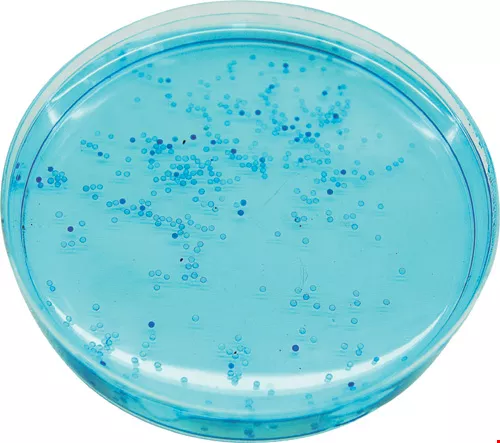
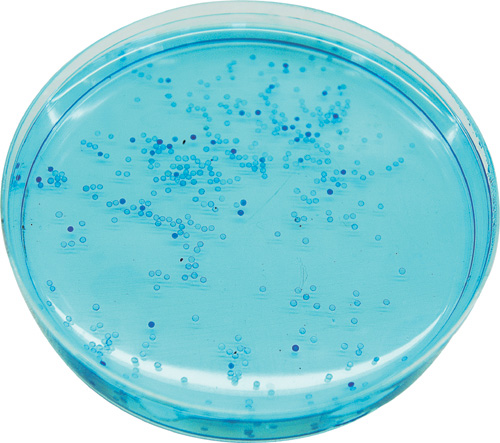

Fluorescent Fish Put Spotlight on Taiwan
Chang Chiung-fang / photos Chi Kuo-chang / tr. by Minn Song
February 2005

Everyone agrees that we must work hard on improving the economy and furthering our diplomatic efforts. Taiwan, all agree, must come through and let the whole world know. But saying it is easy, while doing it is hard.
Unexpectedly, a fish has made a major contribution to these objectives. The transgenic fluorescent fish invented by Tsai Huai-jen, director of National Taiwan University's Institute of Molecular and Cellular Biology, has not only been a significant achievement in Taiwan's biotechnology efforts, but has also put Taiwan in the spotlight on the international stage.
In the past year, journalists from the Far Eastern Economic Review, Wall Street Journal, Science, Time, the UK's Animal Planet channel, and the France 3 channel have come to Taiwan. Most of the reporters had never been to Taiwan, and their impression of it had been confined to bickering in its legislature and natural disasters such as earthquakes and floods. On this occasion, they made the long journey to Taiwan in order to report on something very different-the world's first transgenic fluorescent fish.
In November 2003, these glowing fish were selected by Time magazine as one of the year's 40 coolest inventions. This biotechnology breakthrough was the only invention from Taiwan listed along with amazing international inventions such as an invisibility cloak, skydiver wings, salmon-skin leather swimwear, a nasal-mist flu shot, and the Qrio robot.

A fortuitous accident resulted in spectacular fluorescent fish.
Bright prospects
Black or blue light of wavelengths between 350 and 400 nanometers (commonly used in detecting counterfeit bills or for lighting effects in nightspots) excites phosphorescent proteins in the genetically modified zebra fish, a docile variety with beautiful stripes, and big-bellied medaka. The small fish, measuring just three centimeters in length, swim about the aquarium, emitting a spectrum of strange colors, like a rainbow flashing in a night sky. The effect is not only spectacular, but full of mystery.
Fish for Chinese are a symbol of good fortune. Chinese expressions that include the character for fish express everyone's desire for bright prospects and affluence. Even a dream about fish is interpreted as a favorable omen. Besides attracting good luck, an aquarium with quiet and elegant-looking fish helps relieve tension for people living in crowded, stressful urban environments. It could be called a happy coincidence that Tsai's research, apparently so completely removed from the marketing of pets, has provided several popular additions to the lineup of pet fish choices.
In 2001, Taikong Group-a trading company specializing in aquatic creatures, pet supplies, and books-obtained rights to Tsai's technology. After announcing the world's first transgenic fluorescent fish, the company launched a series of new varieties-from ones that glowed a solid green, solid red, red rosettes, purple rosettes, or solid gold to one that glowed red at its head and green at its tail end. All told, nearly ten varieties of the transgenic fluorescent fish have made their debuts.
Fisher Lin, manager of Taikong's biotechnology R&D department, indicates that the company planned to introduce a gold-glowing fish on the market before this coming Chinese New Year holiday. This variety, called the "TK-1 golden night pearl," carries genes for both green and red fluorescence. When the two colors intermingle, the result is an auspicious, appealing golden glow. The company expects excellent market response to the new variety.

A fortuitous accident resulted in spectacular fluorescent fish.
A happy accident
While it might sound a little fantastic, the invention of the fluorescent fish was the unexpected outcome of research that Tsai was performing on embryonic development and genetic transfers in fish.
Tsai, along with Hsieh Feng-chou, chairman of NTU Hospital's Department of Obstetrics and Gynecology, and internist Ho Yi-lun, have worked together for several years, using genetically modified fish as a model for studying human heart and eye disorders. Why use fish to conduct research on the human heart and eye? Because though the mice commonly used in laboratories are structurally more similar to human beings, fertilization and gestation take place inside the body in mammals. At birth, the heart and eyes are already fully developed, so that there is no opportunity to directly observe the development process.
On the other hand, fish eggs develop outside the mother's body, and the entire process from insemination to completion of embryonic development takes only two days, giving fish advantages such as rapid growth and short generational cycles. Even better, fish embryos are transparent, making them suitable for microinjection, while color marking of organs such as the eyes and heart can make their development even easier to observe and track.
Invertebrates possess no heart, as this organ first made its appearance in fishes. A fish's heart contains a single ventricle and auricle, making it a primordial version of the human heart (which has two ventricles and two auricles). As a consequence, using fish for basic research is very helpful in areas such as drug screening or studying mechanisms of action. And since the genomes of zebra fish and medaka have already been sequenced, they are the near-unanimous choice of experimental animal in medical research.
In order to resolve the gene insertion problem in this research, Tsai used a phosphorescent protein found in jellyfish as a "reporter gene." Unexpectedly, once implanted in the fish body, the protein glowed even more strongly and beautifully-this was the birth of the transgenic fluorescent fish. News of this unanticipated discovery in a medical laboratory spread through the biotech industry, eventually proving a boon to pet fish vendors. These vendors sought cooperation with researchers, and fluorescent fish thereby found a way out of the laboratory. Taikong also created a gene and fish germplasm bank especially for the fluorescent fish, and introduced these fish on the market after propagating them in large numbers.
Simply put, transgenic fluorescent fish are created by microinjecting the genes for a protein that glows green in jellyfish, or a coral protein that glows red, into the eggs of medaka or zebra fish. These genes then replicate within the embryo, so that the host fish emits the same glow as the jellyfish or coral where the genes originated.
However, the success rate for accurately inserting the gene into the target chromosome and inducing its expression is not high. The research team led by Tsai had to repeatedly assemble and test combinations of gene segments before finally successfully breeding a transgenic fish whose entire body emitted a green glow.
And even a foreign gene implanted in the same position may aggregate with copies of itself inside the fish embryo, forming a multi-molecular complex, before integrating into a chromosome. Therefore, the number of fluorescence genes in individual fish can differ, and the amount of fluorescent protein will also vary. "In order to achieve the best results, the fish targeted for a gene implants must be first be screened, which is an arduous process," says Taikong's Lin.

The fluorescent fish was named one of the world's coolest inventions of 2003. Under blue light, the body of the fluorescent fish gives off an impressive red and green glow
Protecting the ecosphere
Hearing the term "transgenic fish" immediately brings to mind the question of the impact such fish may have on the ecosphere.
In fact, Tsai has been involved in research on transgenic fish for many years. More than ten years ago, Tsai's research subject was edible aquatic species. He worked on making fish and shellfish such as Taiwanese abalone grow faster and yield higher-quality flesh, and on giving shrimp better disease resistance. Although his initial development efforts were successful, he did not pursue this research direction further, the main reason being the difficulty of manipulating transgenic fish.
"The main areas for concern are twofold. The first is food safety and the second is the environmental impact," explains Tsai. Research remains to be done on food safety issues, as the implantation of foreign genes may produce proteins that human beings have never encountered, causing allergic reactions in people who consume them.
In addition, caution must be exercised to minimize environmental impact, as most widely consumed fish are raised in publicly accessible environments. Even more dangerous is the practice of raising fish in cage nets in the open sea. Should the net rupture, transgenic fish would enter the natural environment, with unpredictable consequences.
Transgenic fluorescent fish are a type of pet fish, and though there are consequently no food safety concerns, any possible impact on the ecosphere cannot be ignored. In order to avoid ecological damage, after the introduction of transgenic fluorescent fish, Tsai spent nearly two years developing neutering techniques. "At present, only Taiwan can achieve 100% sterilization of medaka and zebra fish," says Tsai. He also explains that the challenges posed by this technology are not less formidable than those presented by gene transfer itself.
Although the fluorescent fish on the market have been sterilized, and cannot produce offspring, if by chance one such fish should be released into a stream or reservoir, would it affect the natural ecology? This is especially important to consider in view of the fact that although zebra fish are native to various southeast Asian countries, and while Taiwan has a native variety of medaka, the Japanese variety of medaka with a more transparent body has been chosen to produce the transgenic fluorescent fish as it has greater visual appeal. There are numerous cases of foreign species competing with native organisms for food, and their lack of natural enemies may lead to ecological imbalances. They may even consume native species, causing extensive damage such as extinctions. The ecological havoc precipitated by the introduction of the Amazonian apple snail provides a good example of such a chain of events.
"There are no such concerns with transgenic fluorescent fish," counters Taikong's Lin. Even if they enter the natural environment, their light-emitting bodies would turn them into very easy prey for predators, making it difficult for them to survive. Their glow is produced by a naturally fluorescent protein, and not a manmade compound, so that there would be no danger posed to any fish that might eat them.

The fluorescent fish was named one of the world's coolest inventions of 2003. Under blue light, the body of the fluorescent fish gives off an impressive red and green glow
A star is born
After dispelling ecological concerns, and returning to business issues, what benefits can fluorescent fish bring?
"Pet fish rely on their visual impact for their appeal, so beauty is a basic requirement," points out Bill Kuo, Taikong's administrative and finance manager. Deep-sea tropical fish are more brilliantly colored, but because the water in fish aquariums must be changed often and man-made sea salts are very expensive, the cost of raising such fish is considerable. In addition, companies must capture the fish from the sea, increasing the risk of ecological damage. In 2003, the Disney animated film Finding Nemo resulted in a fad for raising saltwater fish such as clown fish and Picasso fish. This turn of events, surely not anticipated by the moviemakers, was at odds with the protection of the marine ecosphere urged by the film itself.
Though freshwater fish are easier to raise than saltwater fish, most are unfortunately bland in coloration, and therefore unable to arouse the interest of consumers. As a consequence, some companies have resorted to injecting food coloring into the bodies of freshwater fish to give them a more colorful appearance. However, doing so requires "processing" each fish individually, not only taking time but also resulting in high failure rates. Injected coloring retains its effect for only three weeks to a month before degrading and fading. Because of the requirements of the experiments he was performing, Tsai accidentally turned small and seemingly inconspicuous stream-inhabiting fish into new type of pet fish that give off a mesmerizing phosphorescent glow. Not only were these fish selected as one of the world's coolest inventions of 2003, but they transformed the neglected medaka into a celebrity among fishes.

Taikong Corporation has created a fish germplasm bank, then bred, reproduced and neutered transgenic fluorescent fish for the pet fish market.
From lab to market
However, the road from laboratory success to commercialization is an arduous one.
"At first, no one thought much about its prospects," Lin says. Initially, if an aquarium with a single green fluorescent fish was fitted with a short wavelength black light, the other fish in the aquarium could not be seen. Such obstacles to broader acceptance were gradually removed as other types of fluorescent fish and accessories were introduced. Once artificial propagation was practiced to produce the fish in large numbers, the price of fluorescent fish dropped from NT$600 to under NT$200, and then to the current NT$59. With these price declines, sales have grown steadily.
The Taiwanese market does not present much of a problem, but foreign sales do. The US, Japan, and Europe are the main markets for pet fish, but many countries are cautiously evaluating whether to allow sales of the fish, and some have even banned their sale already.
Kuo has analyzed the situation, finding that most countries have not explicitly banned the sales and production of transgenic pet fish. However, because nobody had applied biotechnology to pet fish, a period of time is needed for assessment.
Though Tsai has been frustrated by the numerous obstacles to foreign sales, he expresses understanding. He points out that in the past few centuries, the agricultural and fishery industries have used hybrid breeding techniques to intermingle thousands or even tens of thousands of genes. With luck, a good breed results from these efforts. However, there is also the possibility of losing favorable characteristics. The advantage of gene transfer is that it limits change to individual genes and targets specific species. Except for the characteristic coded for by the gene, other characteristics of the host species are left completely unchanged.
"Hybridization, which involves the recombination of thousands of genes, is acceptable to everyone, and even considered 'natural.' However, people are very concerned about transferring a single gene between species," says a puzzled Tsai. Still, looking at the issue in another way, he admits that this sort of societal pressure is a good thing, in that it can at least give those who control technology a humbler perspective, and keep them from destroying the environment.

A fortuitous accident resulted in spectacular fluorescent fish.
A little fish hits it big
Looking to the future, besides working harder to remove obstacles to foreign sales by showing that transgenic fluorescent fish pose no ecological threat, Taikong must also maintain its technological leadership.
In fact, researchers in Singapore began R&D on fluorescent zebra fish earlier than those in Taiwan. However, the results were less than ideal. They were not able to achieve 100% sterilization, and their efforts were overtaken by those in Taiwan. Although Taikong has applied for patents for its gene implantation and sterilization technologies, "the challenge is only beginning."
Lin predicts that with the popularity of fluorescent fish, other companies are bound to follow Taikong's lead. For a company to stay ahead, it cannot rely solely on its own efforts, but must work with local research organizations. "Cooperation between industry and academia can provide benefits to both," says Lin. Taikong must continue to develop fluorescent fish with even more colors, and even apply the technology to larger fish. The fluorescent angelfish recently announced by the Marine Research Station at the Academia Sinica's Institute of Zoology, boasting a green backbone and red flesh, will be one prize for which vendors will compete.
Besides red and green, "blue is also very important," says Tsai. If the ability to give fish the primary colors of red, blue, and green can be developed, then these colors can be combined to create a rainbow fish with all the colors. However, the intensity of blue that can currently be produced is not good, being visible only under a fluorescence microscope. Work remains to be done before this technology can be used with pet fish.
Lin explains further that while the gene for blue fluorescence is also taken from coral, the hue it produces is barely distinguishable from green to the naked eye. In the future, the search will be extended to crustaceans in the hope of finding a gene for blue fluorescence that provides a greater intensity.
Kuo relates that though Taiwan's small pet fish market is valued at just NT$200-300 million a year, the transgenic fluorescent fish earned Taikong NT$10 million in income in 2003. In 2004, sales have been even better, reaching NT$47 million including royalties from foreign licensees.
The success of the little fish is not restricted to the tangible benefit it provides, as the intangible benefit of favorable publicity for Taiwan is also valuable. Fluorescent fish have not only given Taiwan coverage in many important international media outlets, but inventor Tsai Huai-jen was even invited to be on a foreign call-in show on its account. Junior high school teachers and elementary school students in the US have written with questions about the fluorescent fish. Even a university student in faraway South Africa wrote to obtain a fish, hoping to see this new wonder for himself.
Just like the fluorescent fish giving off light in the darkness, Taiwan, while small, "has suddenly made itself seen!" proudly says Tsai, the man with the Midas touch with fish.

In the photograph, the part glowing green is the fish's heart. (courtesy of Tsai Huai-jen)

The fluorescent fish was named one of the world's coolest inventions of 2003. Under blue light, the body of the fluorescent fish gives off an impressive red and green glow

This red- and green-glowing transgenic zebra fish has not yet been introduced on the market. (courtesy of Tsai Huai-jen)

The fluorescent fish was named one of the world's coolest inventions of 2003. Under blue light, the body of the fluorescent fish gives off an impressive red and green glow

A fortuitous accident resulted in spectacular fluorescent fish.

Brilliant fluorescence, beautiful fish-having spent his life immersed in biotechnology research, Tsai Huai-jen, director of NTU's Institute of Molecular and Cellular Biology, has become a celebrity because of his fluorescent fish.
Taikong Corporation has created a fish germplasm bank, then bred, reproduced and neutered transgenic fluorescent fish for the pet fish market.

@List.jpg?w=522&h=410&mode=crop&format=webp&quality=80)




